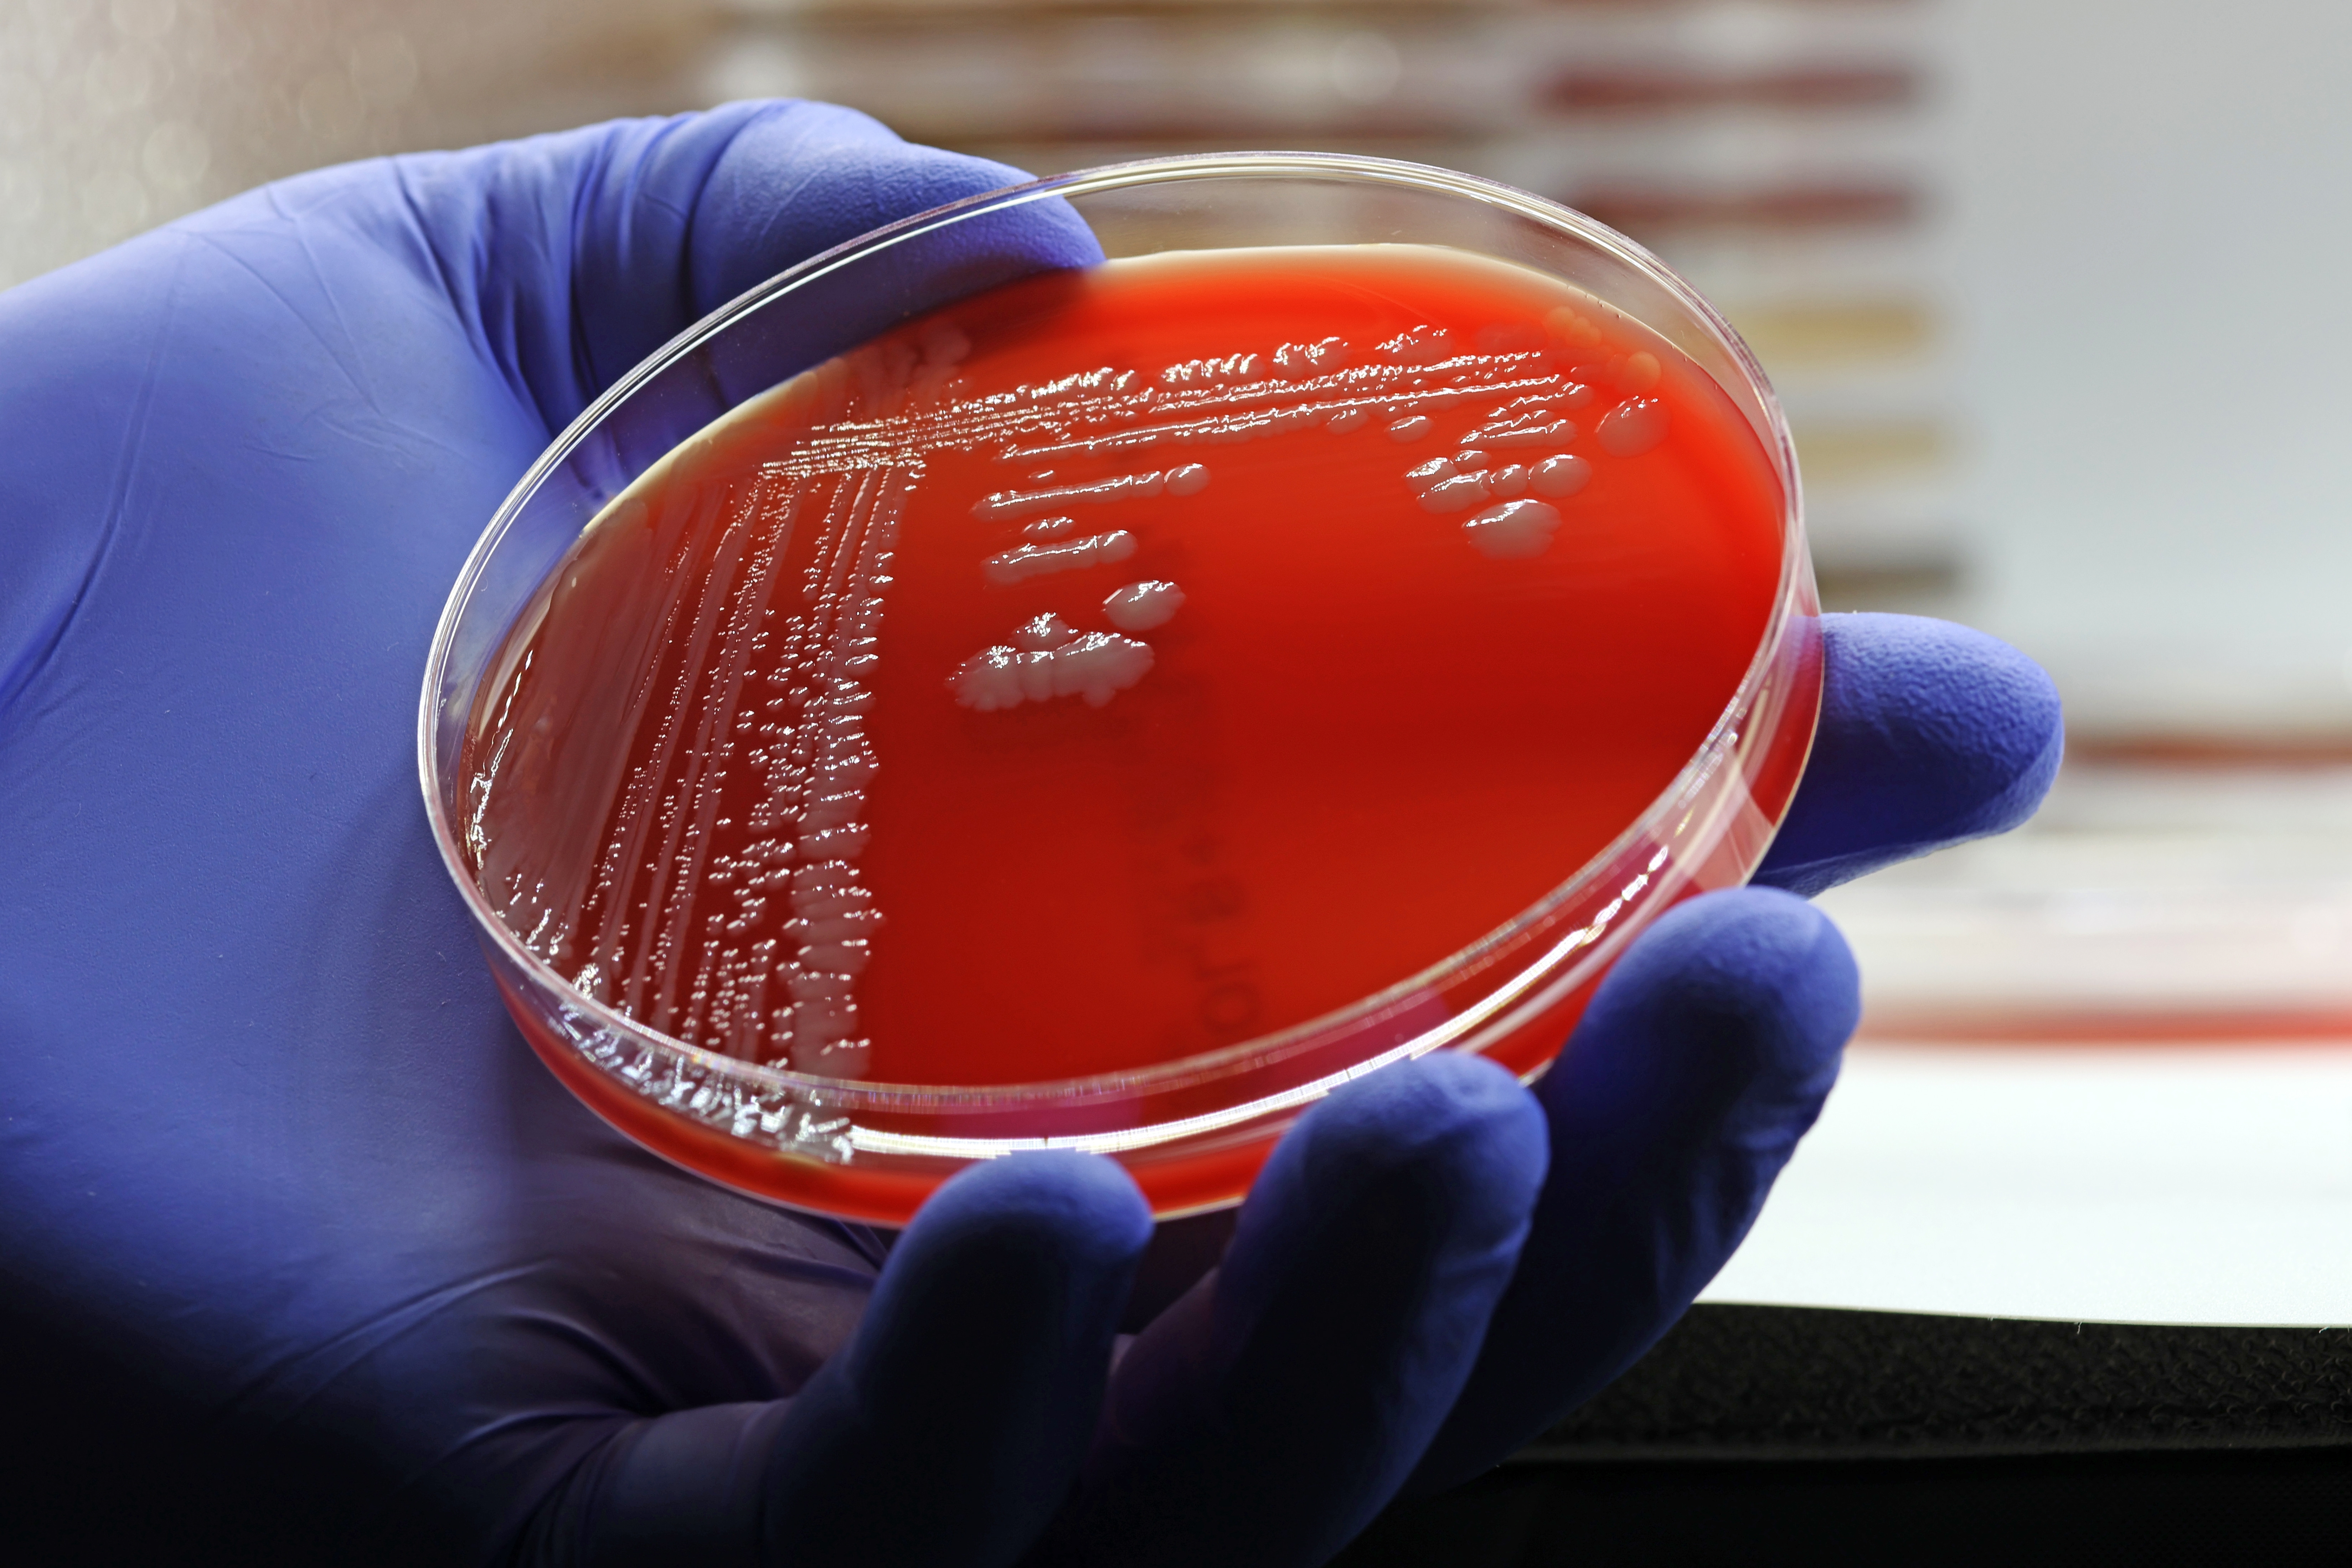
„Fantoma incurabilă”. O genă care face bacteriile rezistente la orice antibiotice se răspândește în spitale din toată lumea

Paradox grav: cancerul face ravagii în România, dar accesul la studii clinice rămâne extrem de redus
România este subreprezentată în studiile clinice oncologice, în pofida amplorii cancerului şi a uneia dintre cele mai ...
Citeste mai mult ›
Citeste mai mult ›